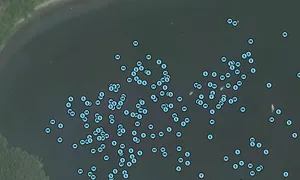

TRUE NORTH, MMSI: 367637470
 United States
United States
Follow the journey
Images of TRUE NORTH
Journey statistics
Preferred harbour type
2025
100% marina
natural harbour 0%
2024
100% marina
natural harbour 0%
2023
44% marina
natural harbour 56%
2020
15% marina
natural harbour 85%
2019
46% marina
natural harbour 54%
2018
35% marina
natural harbour 65%
2017
29% marina
natural harbour 71%